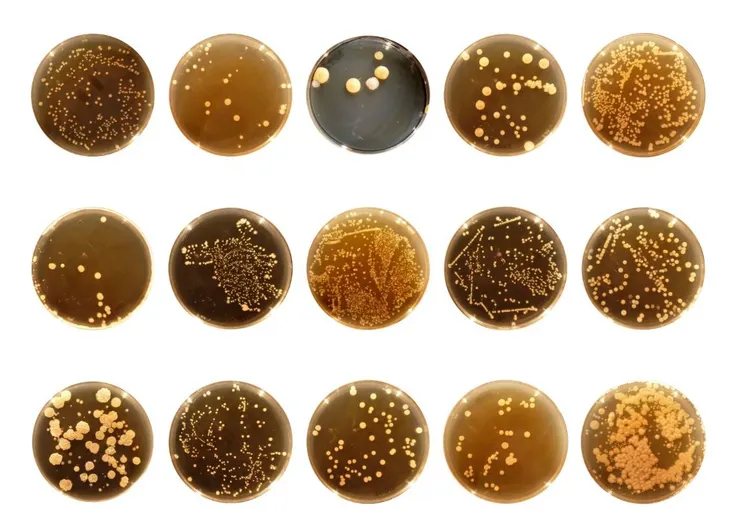
vocus｜新世代的創作平台

肚臍位在肚皮的中心點,是阿罵認為身體最脆弱的一個器官,就算全球暖化到北極熊想脫外套,阿罵也要你睡覺蓋肚臍。更不用說消化不良要萬金油擦肚臍,暈車要酸梅塞肚臍,頭痛要用鹽抹肚臍,各式各樣,花招百出。
從文化的角度來看,有些文化認為肚臍好羞羞,應該遮起來,也有些文化覺得肚臍好重要,所謂的三點中的第三點應該就是肚臍了吧~(該說他們天真爛漫嗎?沒錯 他們就是史前時代的日本人...)。更有認為肚臍美美的,就是要穿珠戴環,用力的在你面前舞力全開(阿拉伯文化的肚皮舞)。既然這麼眾說紛紜,就讓我們好好來認識一下肚臍。
肚臍的發育早在胚胎四週大的時候就開始了,一開始只是個環狀的折,別小看他,就因為有了這個小折子,卵黃囊才能被清楚區隔成兩半,身體裡的那一半形成未來的腸道,身體外的那一半則是在胎盤形成之前,為胚胎提供養份的正港卵黃囊。胎兒快出生的時候,卵黃囊已經消失了,只留下連接胎盤的血管。所以每個人的肚臍上都留有一個臍帶靜脈痕跡在12點鐘方向,兩個臍帶動脈痕跡在4點和8點方向,只是可能都被皺摺蓋住了吧...。
肚臍位在腸骨稜(iliac crests)的上緣,第3, 4腰椎(L4 vertebra)的對面。從胸骨劍凸往下畫一條線到恥骨,肚臍落在60%的位子(快看看你的肚臍有沒有住對地方)。從腹腔內部看,肚臍有一條圓韌帶(ligamentum teres)與上方的肝臟相連,下方有一條在胚胎發育時期與膀胱相連的遺跡(不知道這是不是跟牆編每次伸手去摳肚臍的時候,都有種想尿尿的感覺有關,有人有一樣的症頭嗎?該不會又只有我活在不同的世界裡吧 ....)。
除了自己的肚臍,你有沒有觀察過別人的肚臍是什麼形狀的呢?有沒有發現,有些人的肚臍是凸的, 有些人是個圓洞,有些人是條小縫,有些人還寫了個T字在上面。雖然有點不太對勁,但是真有研究分析了百來位女性肚臍照片和吸引力間的關係。結果發現T字肚臍最受歡迎,凸肚臍則最差...。別擔心。現在醫美這麼發達,真的有肚臍整形手術, 幫你整得漂漂亮亮,自信滿滿....
既然肚臍可以說是每個人出生後的第一個疤痕,聰明的醫生當然一定會好好利用這個小東西,幫你開刀不留痕跡。一些婦科的腹腔鏡手術, 也可以在肚臍上操作喔。
在肚臍裡,不意外的又住了一群可愛的細菌們。位在北加州的滷蛋實驗室(Ron Dunn Lab)已經在2011年展開了肚臍菌計畫(Belly Button Biodiversity, BBB project),要來好好的戶口普查一下這些菌。結果發現了2368種菌,其中半數以上都是從來沒有被發現過的菌種,也有只在日本的土裡或是北極的冰帽裡發現過的菌種,肚臍裡儼然是個小世界啊~這還只是計畫剛開始,抽查了60個人的結果,滷蛋實驗室還繼續在線上徵求志願者,在家中依照說明,以棉花棒採樣,寄送給他們分析(我們衷心期盼,每一位志願者都乖巧的沒有拿棉花棒亂挖別的洞)。
或許你也想問,肚臍裡本身就養了那麼多小寵物了,那我們到底該不該清潔肚臍呢?滷蛋實驗室給的建議是,免!除非你肚臍有感染過的歷史,不然也是不用特別去用力清潔,自然隨意就好......。牆編覺得.....為了保持吸引力,有機會露肚臍給大家欣賞之前,還是把那些不太好看的東西清一清,好像比較合理...。不過要記住,肚臍裡面和腹腔內部只隔了相對薄的皮膚和肌肉,不論要清潔還是幹嘛(聽說有人的敏感帶在肚臍...)都要溫柔的對待它,免得感染,嚴重起來很可怕的....
資料來源:
https://www.theatlantic.com/.../1-458-bacteria.../266360/
http://robdunnlab.com/projects/belly-button-biodiversity/
https://insights.ovid.com/pubmed?pmid=10627008
https://plasticsurgerykey.com/the-umbilicus-in-body.../
圖片來源:
https://plasticsurgerykey.com/deep-and-superficial.../
https://en.wikipedia.org/wiki/Omphalos
https://www.stylecraze.com/.../simple-ways-to-lose-tummy.../
https://www.healthline.com/health/belly-button-types
https://pt.slideshare.net/.../surgical-anatomy-of.../48...